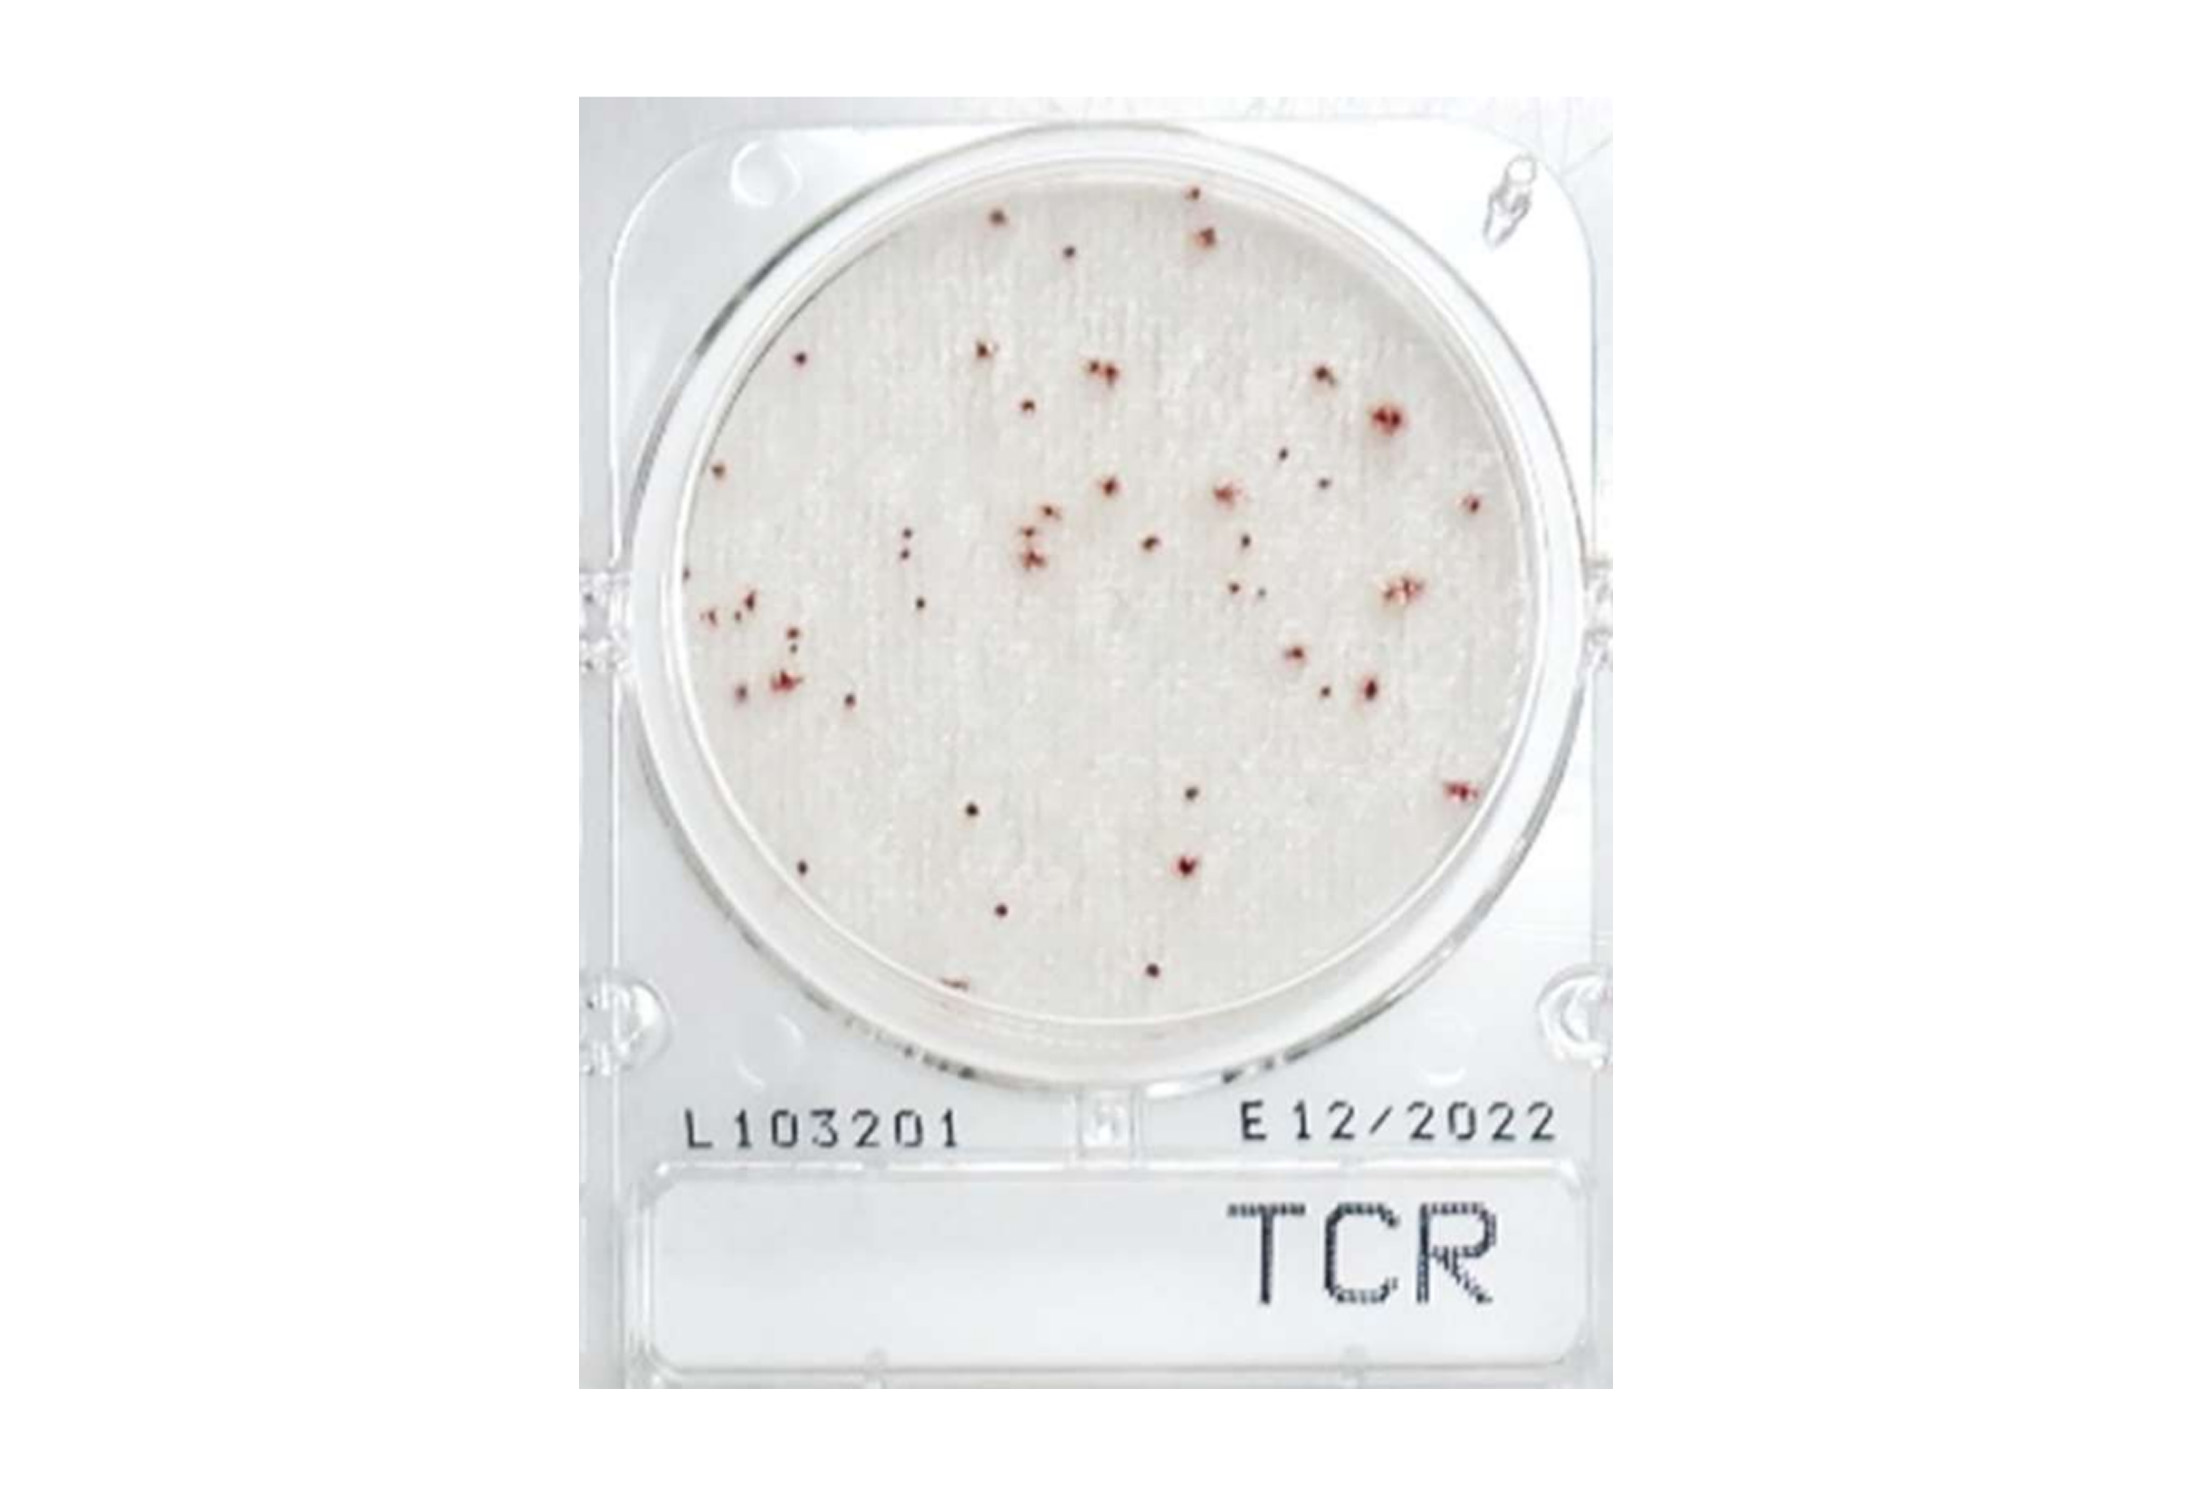

ชื่อผลิตภัณฑ์
Compact Dry TCR
แบรนด์
SHIMADZU DIAGNOSTICS CORPORATION
คำอธิบาย
เป็นจานอาหารเลี้ยงเชื้อสำเร็จรูป สำหรับการตรวจหาจำนวนแบคทีเรียทั้งหมด ประกอบด้วยอาหารเลี้ยงเชื้อสำเร็จรูปแบบแห้ง non-selective medium และสารบ่งชี้ที่มีความจำเพาะเจาะจง สามารถรายงานผลการทดสอบได้อย่างรวดเร็วภายใน 24 หรือ 48 ชั่วโมง
คุณสมบัติ
- หลังจากหยดตัวอย่าง 1 มล. ลงไปบนเพลท ตัวอย่างจะกระจายตัวอัตโนมัติภายใน 2-3 วินาที โดยไม่ต้องใช้อุปกรณ์เพิ่มเติม
- บรรจุในซองที่ผลิตจากอลูมิเนียม ภายในมีแผ่นดูดความชื้น และผ่านการฆ่าเชื้อด้วยรังสีแกรมมา
- ขนาดเส้นผ่าศูนย์กลาง ประมาณ 5 เซนติเมตร พื้นที่การเจริญเติบโต 20 ตารางเซนติเมตร
- ตัวเพลทผลิตจากพลาสติกประเภท Polystyrene พร้อมฝาปิดแบบใสที่มีความแข็งแรง และป้องกันการปนเปื้อนข้าม
- อายุการใช้งาน 18 เดือน จากผู้ผลิต เก็บไว้ที่อุณหภูมิห้อง 1-30 °C
- การกำจัดสามารถฆ่าเชื้อด้วยหม้อนึ่งแรงดันไอน้ำ (Autoclave) อุณหภูมิ 121 °C นาน
30 นาที - สามารถวางเพลทซ้อนทับได้ไม่จำกัดจำนวน ทำให้ประหยัดพื้นที่ในตู้บ่ม
- สามารถนับจำนวนแบบคาดคะเนได้ โดยนับ 3-4 ช่อง หาค่าเฉลี่ยแล้วคูณด้วยขนาดพื้นที่ทั้งหมด (1 ช่องมีพื้นที่เท่ากับ 1x1 ซม. โดยดูช่องสี่เหลี่ยมด้านหลังจาน)
- มีเอกสารรับรองคุณภาพผลิตภัณฑ์ (Certificate of Analysis / COA)
- เป็นผลิตภัณฑ์ที่ผลิตโดยโรงงานที่ได้รับรองมาตรฐาน ISO 9001:2000
ข้อมูลจำเพาะ
- Target organism : Total Viable Counts (TVC) or Aerobic Counts
- ระยะเวลาบ่ม : อุณหภูมิ 35 + 1 oC (for all food matrices except dairy products)
อุณหภูมิ 35 + 1 oC or 32 + 1 oC (for dairy products) - การเก็บรักษา (Storage temperature) : เก็บที่อุณหภูมิห้อง (อุณหภูมิ 1-30 °C)
Approved
- อยู่ระหว่างการขอการรับรอง AOAC PTM certification
Package
- Compact Dry “Nissui” TCR แบบ Box จำนวน 40 plates
- Compact Dry “Nissui” TCR แบบ Case จำนวน 240 plates
(ภายในซองบรรจุ 4 เพลทต่อ 1 ซอง)